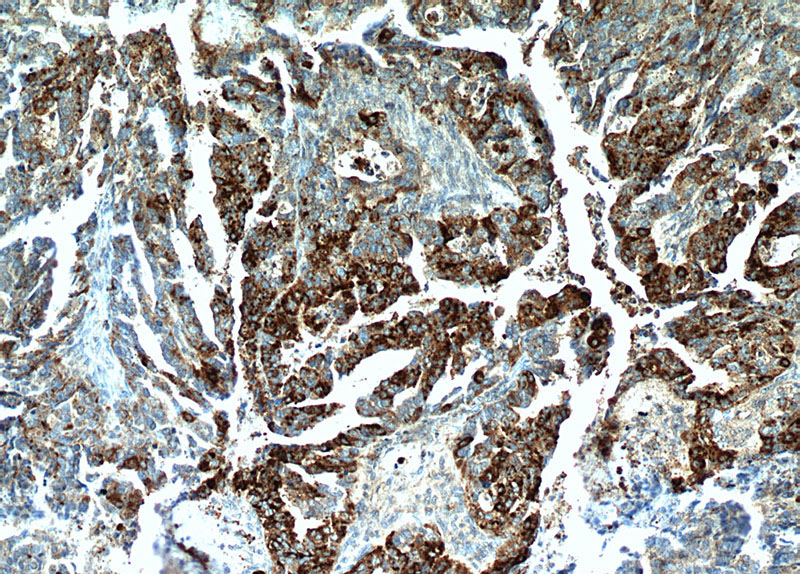
Immunohistochemical of paraffin-embedded human ovary tumor using Catalog No:109499(COX7A2L antibody) at dilution of 1:50 (under 10x lens)

-
Product Name
COX7A2L antibody
- Documents
-
Description
COX7A2L Rabbit Polyclonal antibody. Positive WB detected in mouse brain tissue, rat brain tissue, rat liver tissue. Positive IHC detected in human ovary tumor tissue, human breast cancer tissue. Observed molecular weight by Western-blot: 14 kDa
-
Tested applications
ELISA, WB, IHC
-
Species reactivity
Human,Mouse,Rat; other species not tested.
-
Alternative names
COX7a related protein antibody; COX7A2L antibody; COX7AR antibody; COX7RP antibody; EB1 antibody; SIG81 antibody
-
Isotype
Rabbit IgG
-
Preparation
This antibody was obtained by immunization of COX7A2L recombinant protein (Accession Number: XM_047446291). Purification method: Antigen affinity purified.
-
Clonality
Polyclonal
-
Formulation
PBS with 0.1% sodium azide and 50% glycerol pH 7.3.
-
Storage instructions
Store at -20℃. DO NOT ALIQUOT
-
Applications
Recommended Dilution:
WB: 1:200-1:2000
IHC: 1:20-1:200
-
Validations
Immunohistochemical of paraffin-embedded human ovary tumor using Catalog No:109499(COX7A2L antibody) at dilution of 1:50 (under 10x lens)

Immunohistochemical of paraffin-embedded human ovary tumor using Catalog No:109499(COX7A2L antibody) at dilution of 1:50 (under 40x lens)

mouse brain tissue were subjected to SDS PAGE followed by western blot with Catalog No:109499(COX7A2L Antibody) at dilution of 1:600
-
Background
Cytochrome c oxidase (COX) is the terminal component of the mitochondrial respiratory chain, catalyzes the electron transfer from reduced cytochrome c to oxygen. The mitochondrially encoded subunits function in electron transfer, and the nuclear encoded subunits may function in the regulation and assembly of the complex. COX7A2L (cytochrome c oxidase subunit 7A-related protein), also known as COX7AR or COX7RP, is an inner mitochondrial membrane protein. This gene is expressed in all tissues, and upregulated in a breast cancer cell line after estrogen treatment. Recently it was found that DNA mythylation of COX7A2L had a significant association with therapy response in patients with breast cancer. In Alzheimer’s disease the expression of COX7A2L was reduced.
-
References
- Aichler M, Elsner M, Ludyga N. Clinical response to chemotherapy in oesophageal adenocarcinoma patients is linked to defects in mitochondria. The Journal of pathology. 230(4):410-9. 2013.
- Li N, Bates DJ, An J, Terry DA, Wang E. Up-regulation of key microRNAs, and inverse down-regulation of their predicted oxidative phosphorylation target genes, during aging in mouse brain. Neurobiology of aging. 32(5):944-55. 2011.
- Elsner M, Rauser S, Maier S. MALDI imaging mass spectrometry reveals COX7A2, TAGLN2 and S100-A10 as novel prognostic markers in Barrett's adenocarcinoma. Journal of proteomics. 75(15):4693-704. 2012.
Related Products / Services
Please note: All products are "FOR RESEARCH USE ONLY AND ARE NOT INTENDED FOR DIAGNOSTIC OR THERAPEUTIC USE"
